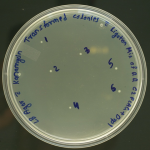

II. CrRNA synthesis (expression):
II. CRISPR-associated (Cas-9) proteins
III. Repair (Double-Stranded Break Repair Mechanisms)
A. Non-homologous end joining (NHEJ):
B. Homology-directed repair (HDR):
- CRISPR (Clustered Regularly Interspaced Short Palindromic Repeat) is a nucleotide repetitive sequence followed by short spacer segments integrated upon exposure to invading pathogens in the genome of prokaryotes.
- CRISPR is adaptive immunity in prokaryotes to defend against viral infection and bacteriophages.1
- CRISPR can be used as a genetic engineering tool in which DNA is deliberately inserted, removed, or modified in living cells.

There are three main stages by which the CRISPR defense mechanism defends bacteria from reoccurring viral attacks:
- Adaptation (spacer acquisition)
- CrRNA synthesis (expression)
- Target interference.

Short viral DNA segments, known as spacers, require Cas1 and Cas2 to capture and catalytically insert into a genomic area known as the CRISPR array to immunize bacterial cells during the adaptation process. Thus, spacers function as a genetic memory for previous viral infections.2
II. CrRNA synthesis (expression):
The CRISPR transcription process begins in the leader region of the host cell, containing promoter elements and regulatory proteins. The CRISPR array is transcribed into a precursor crRNA, which is processed into mature guide crRNAs, each with a spacer and repeat sequence. In CRISPR/Cas9 systems, tracr RNA is required for processing pre-crRNA, forming an RNA duplex with the Cas9 protein. This duplex is recognized and processed by RNase III, generating an intermediate form of crRNA. Further maturation involves 5′ trimming, resulting in mature small guide RNAs for target DNA recognition and cleavage.3
The CRISPR-Cas system uses target interference, where the crRNA identifies a protospacer region in the target DNA and triggers its degradation by specific Cas nucleases. In type II (CRISPR/Cas9) systems, interference requires a protospacer-adjacent motif (PAM) sequence.3
CRISPR/Cas system can be classified into two classes: Class I (type I, III, and IV) and Class II (type II, V, and VI) based on the structure and functions of Cas-proteins. Class I systems are made up of Cas-protein complexes with many subunits, whereas class II systems only use one Cas-protein. As type II CRISPR/Cas-9 has a relatively basic structure, extracted from Streptococcus pyogenes (SpCas-9), the Cas-9 protein was the first and extensively studied Cas protein used in genetic engineering.4 It is referred to as a genetic scissor since it is a large multi-domain (1368 amino acids) DNA endonuclease that cleaves target DNA to generate a double-strand break.5
The CRISPR/Cas-9 system requires two fundamental components:
- Guide RNA (gRNA)
- CRISPR-associated (Cas-9) proteins.
It is composed of two parts: CRISPR RNA (crRNA) and trans-activating CRISPR RNA (tracrRNA). The crRNA( 18-20 base pairs long) specifies the target DNA by pairing with the target sequence, whereas tracrRNA is a long stretch of loops that acts as a binding scaffold for Cas-9 nuclease. In prokaryotes, the guide RNA has been used to target viral DNA, but in the gene-editing tool, it can be synthetically built a single guide RNA (sgRNA) by combining crRNA and tracrRNA to target practically any gene sequence that needs to be edited.5
II. CRISPR-associated (Cas-9) proteins
Cas-9 has two regions, known as the recognition (REC) lobe and the nuclease (NUC) lobe. The REC lobe is composed of REC1 and REC2 domains which bind guide RNA (gRNA), while the nuclease (NUC) lobe consists of RuvC, HNH, and Protospacer Adjacent Motif (PAM) interacting domains. The RuvC and HNH domains are used to cleave each single-stranded DNA, whereas the PAM interaction domain gives PAM specificity and starts the binding process to the target DNA.6
The mechanism of CRISPR/Cas-9 genome editing can be generally divided into three steps:
- Recognition
- Cleavage
- Repair

The target sequence in the gene of interest is recognized by the 5ʳcrRNA complementary base pair component of designed sgRNA to activate Cas-9. If there is no sgRNA, the Cas-9 protein remains inactive. At a site 3 base pair upstream to PAM, the Cas-9 nuclease creates double-stranded breaks (DSBs). The PAM sequence which is a short (2-5 base pair length), conserved DNA sequence (varies on the bacterial species) lies downstream of the cut site. Cas-9, the most commonly used nuclease in genome editing, recognizes the PAM sequence at 5ʹ-NGG-3ʹ (where N can be any nucleotide base).7
After Cas-9 locates a target site with the right PAM, it initiates local DNA melting, which is followed by the creation of an RNA-DNA hybrid. However, the exact process by which the Cas-9 enzyme melts the target DNA sequence is yet unknown. The Cas-9 protein is then ready to cleave DNA. Target DNA’s complimentary strand is cut by the HNH domain, while its non-complementary strand is cut by the RuvC domain, resulting in blunt-ended DSBs. At last, the host’s cellular mechanism repairs the DSB.5,8
III. Repair (Double-Stranded Break Repair Mechanisms)
In the CRISPR/Cas-9 mechanism, the two pathways for repairing double-strand breaks (DSBs) formed by the Cas-9 protein are non-homologous end joining (NHEJ) and, homology-directed repair (HDR).9
A. Non-homologous end joining (NHEJ):
NHEJ is active during all stages of the cell cycle and promotes the repair of double-strand breaks (DSBs) by enzymatically connecting DNA fragments in the absence of exogenous homologous DNA. While it is the most common and effective cellular repair method, it is also the most prone to error, since it can lead to small random insertions or deletions (indels) at the cleavage site, which can result in the occurrence of frameshift mutations or premature stop codons.9
B. Homology-directed repair (HDR):
HDR is highly precise and involves the use of a homologous DNA template. It is primarily active in the late S and G2 phases of the cell cycle. In CRISPR-gene editing, HDR requires an extensive amount of donor (exogenous) DNA templates containing a sequence of interest. HDR obtains the precise gene insertion or replacement by inserting a donor DNA template with sequence homology at the predicted DSB site.9,10
- Asmamaw, Misganaw, and Belay Zawdie. “Mechanism and applications of CRISPR/Cas-9-mediated genome editing.” Biologics: Targets and Therapy (2021): 353-361.
- Ibrahim, A., MSZ ÖZSÖZ, G. Tirah, and O. Gideon. “Genome engineering using the CRISPR Cas9 system.” J Biomed Pharm Sci 2, no. 127 (2019): 2.
- Hille, Frank, and Emmanuelle Charpentier. “CRISPR-Cas: biology, mechanisms and relevance.” Philosophical transactions of the royal society B: biological sciences 371, no. 1707 (2016): 20150496.
- Liu Z, Dong H, Cui Y, Cong L, Zhang D. Application of different types of CRISPR/Cas-based systems in bacteria. Microb Cell Factories. 2020;19(1):172. doi:10.1186/s12934-020-01431-z
- Mei Y, Wang Y, Chen H, Sun ZS, Ju XD. Recent Progress in CRISPR/Cas9 Technology. J Genet Genomics Yi Chuan Xue Bao. 2016;43(2):63-75. doi:10.1016/j.jgg.2016.01.001
- Yamano, Takashi, Hiroshi Nishimasu, Bernd Zetsche, Hisato Hirano, Ian M. Slaymaker, Yinqing Li, Iana Fedorova et al. “Crystal structure of Cpf1 in complex with guide RNA and target DNA.” Cell 165, no. 4 (2016): 949-962.
- Ceasar SA, Rajan V, Prykhozhij SV, Berman JN, Ignacimuthu S. Insert, remove or replace: A highly advanced genome editing system using CRISPR/Cas9. Biochim Biophys Acta. 2016;1863(9):2333-2344. doi:10.1016/j.bbamcr.2016.06.009
- Jiang F, Doudna JA. CRISPR-Cas9 Structures and Mechanisms. Annu Rev Biophys. 2017;46:505-529. doi:10.1146/annurev-biophys-062215-010822
- Yang H, Ren S, Yu S, et al. Methods Favoring Homology-Directed Repair Choice in Response to CRISPR/Cas9 Induced-Double Strand Breaks. Int J Mol Sci. 2020;21(18):6461. doi:10.3390/ijms21186461
- Liu M, Rehman S, Tang X, et al. Methodologies for Improving HDR Efficiency. Front Genet. 2018;9:691. doi:10.3389/fgene.2018.00691